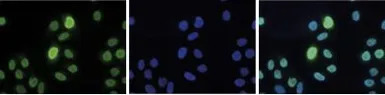
产品细节图片5

相关产品推荐更多 >
万千商家帮你免费找货
0 人在求购买到急需产品
- 详细信息
- 文献和实验
- 技术资料
- 免疫原:
Histone H3 containing trimethylated lysine 9 and the phosphorylated serine 10 (H3K9me3S10p), using a KLH-conjugated synthetic peptide.
- 亚型:
IgG
- 形态:
Liquid
- 保存条件:
Store as concentrated solution. Centrifuge briefly prior to opening vial. For short-term storage (1-2 weeks), store at 4ºC. For long-term storage, aliquot and store at -20ºC or below. Avoid multiple freeze-thaw cycles.
- 克隆性:
Polyclonal
- 标记物:
Unconjugated
- 适应物种:
Human
- 保质期:
12 months from the shipping date of the product.
- 抗原来源:
Human
- 目录编号:
GTX60327
- 级别:
Primary Antibodies
- 库存:
Available
- 供应商:
GeneTex
- 宿主:
Rabbit
- 应用范围:
WB, ICC/IF, Dot, ELISA, ChIP assay
- 靶点:
Histone H3K9me3S10ph (Tri-methyl Lys9/phospho Ser10)
- 抗体英文名:
Histone H3K9me3S10ph (Tri-methyl Lys9/phospho Ser10) antibody - ChIP grade
- 抗体名:
Histone H3K9me3S10ph (Tri-methyl Lys9/phospho Ser10) 抗体 - ChIP grade
- 规格:
50 μl

ChIP analysis of sheared chromatin from 10⁴ HeLa cells treated with colcemid using GTX60327 Histone H3K9me3S10ph (Tri-methyl Lys9/phospho Ser10) antibody - ChIP grade. A titration of the antibody consisting of 1, 5, and 10 μl per ChIP experiment was analysed. Additionally, the same titration was analysed after incubation of the antibody with 5 nmol blocking peptide for 1 hour at room temperature. IgG (5 μg/IP) was used as negative IP control. QPCR was performed with primers for the promoter of the active genes GAPDH and c-fos and for the heterochromatin marker Sat2. This figure shows the recovery, expressed as a % of input (the relative amount of immunoprecipitated DNA compared to input DNA after qPCR analysis).

Dot blot analysis of 0.2 - 100 pmol of the peptides containing other modifications and unmodified sequences of histone H3 using GTX60327 Histone H3K9me3S10ph (Tri-methyl Lys9/phospho Ser10) antibody - ChIP grade.
Dilution : 1:1,000

WB analysis of 15 μg of histone extracts of HeLa cells treated with colcemid (to block the cell cycle in metaphase) using GTX60327 Histone H3K9me3S10ph (Tri-methyl Lys9/phospho Ser10) antibody - ChIP grade.
Dilution : 1:500

ELISA analysis of peptide containing the histone modification of interest using GTX60327 Histone H3K9me3S10ph (Tri-methyl Lys9/phospho Ser10) antibody - ChIP grade.
ICC/IF analysis of 4% PFA fixed HeLa cells using GTX60327 Histone H3K9me3S10ph (Tri-methyl Lys9/phospho Ser10) antibody - ChIP grade.
Green : Primary antibody
Blue : DAPI
Dilution : 1:500
风险提示:丁香通仅作为第三方平台,为商家信息发布提供平台空间。用户咨询产品时请注意保护个人信息及财产安全,合理判断,谨慎选购商品,商家和用户对交易行为负责。对于医疗器械类产品,请先查证核实企业经营资质和医疗器械产品注册证情况。
 文献和实验
文献和实验Chromatin Immunoprecipitation (ChIP)
of formaldehyde in the ChIP method was pioneered by Solomon and Varshavsky (Solomon et al. 1988). In their original studies, the association of histone H4 and RNA polymerase II with the Drosophila hsp70 genes was monitored. Cells were treated with formaldehyde
. 45. Bring the volume to 1 ml with ChIP incubation buffer. 46. Add 5-10 µg of the antibody of choice. In order to control for nonspecific background signal, it is important to include a control precipitation with an (IgG
、TRANSFAC、ECR browser 等) 进行预测,然后确保设计的引物的扩增产物能够横跨这个预测的潜在结合位点。而对于组蛋白修饰(如 Tri-Methyl-H3-K9) 的 ChIP 实验,对引物的扩增范围要求则相对宽松,只要扩增产物能够位于启动子区域或基因转录区域即可。为了方便大家使用,CST 提供很多已经经过验证的检测多个基因的 ChIP primer,请前往 CST 官方网站直接输入 ChIP primer 进行搜索或联系 CST 技术支持(4006-473-287) 获取信息。对于 ChIP
 技术资料
技术资料暂无技术资料 索取技术资料






![SARS-CoV / SARS-CoV-2 (COVID-19) nsp8 antibody [5A10]](https://img1.dxycdn.com/2022/0329/672/0367780215816020453-14.jpg!wh200)


![Brk antibody [2H12B8]](https://img1.dxycdn.com/2022/0328/712/1305443998547500453-14.jpg!wh200)
